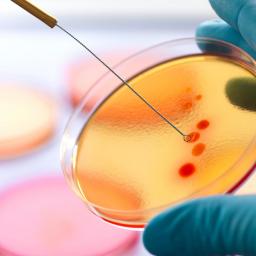

|
by Nicola Davis and Iain Chambers on (#1CYEH)
What makes our speaking voices so distinctive and so recognisable? How can we transform the way we use our voice?Coinciding with a new exhibition at the Wellcome Collection, This Is A Voice is a book by Jeremy Fisher and Gillyanne Kayes offering 99 exercises to train, project and harness the power of your voice.
|
| Link | http://feeds.theguardian.com/ |
| Feed | http://feeds.theguardian.com/theguardian/science/rss |
| Updated | 2026-06-28 18:16 |
 |
by Oliver Milman in New York on (#1CY8M)
Goodall leads coalition calling for Yellowstone’s grizzlies to stay on endangered species list, as Montana hunters set to be offered $50 licenses to shoot themA coalition of scientists headed by renowned conservationist Jane Goodall has implored the federal government to re-think its decision to strip protection from Yellowstone’s grizzly bears, as hunters in Montana are set to be offered $50 licenses to shoot the hulking predators. Continue reading...
|
 |
by Elle Hunt on (#1CY7W)
Rare footage from 11km underwater streams on Youtube from National Oceanic and Atmospheric Administration vesselA live video feed of the Mariana trench – the deepest place on Earth – is proving engrossing viewing for those above sea level.The Mariana trench plunges about 11km (seven miles) deep under the Pacific – further down than the summit of Mount Everest is above sea level. Because of the difficulties in reaching such depths, little is known about the area. Continue reading...
|
 |
by Associated Press on (#1CY1W)
Biotech company Oxitec hopes to repeat a technique used in Brazil to reduce the population of Aedes aegypti mosquitoesThe British biotech company Oxitec and the Cayman Islands government announced plans on Thursday to release millions of genetically modified mosquitoes in the fight against a species that spreads Zika and other diseases.Deployment of the mosquitoes against the Aedes aegypti species in the Cayman Islands is a major advance for Oxitec, which has promoted the method heavily as an environmentally safe way to combat the vectors of mosquito-borne illnesses while confronting public concerns about the technology. Continue reading...
|
 |
by Guardian Staff on (#1CXR5)
An MRI scan on Wednesday, produced by the Freiburg Institute for Musicians’ Medicine, shows opera singer Michael Volle performing a song from the German composer’s opera ‘Tannhäuser’ in real-time. The MRI was produced as a part of ENT (Ear Nose Throat) research project and is part of a study to see what happens inside an opera singer’s mouth when they perform Continue reading...
|
 |
by Lisa O'Carroll on (#1CX4K)
Recognising difference in immune response between survivors and fatalities raises hope that current anti-cancer drug could be used to treat Ebola patientsScientists have identified a key feature in the human immune system that determines whether someone will live or die from Ebola.The breakthrough research brings hope that existing anti-cancer treatments could be used to treat the virus, which killed almost 12,000 in the recent epidemic in West Africa. Continue reading...
|
 |
by Alan Walker on (#1CX24)
The great television presenter and the Queen are celebrating becoming nonagenarians. But there’s nothing random about their health and longevityDavid Attenborough is wrong (a sentence I thought was impossible to write). But when he told the Guardian earlier this week that the reason he had reached the age of 90 was down to luck, he was very wide of the mark.Of course, being Attenborough, he could not be completely mistaken, and he did put his finger on a defining feature of later life: inequality. “When you think, I have relatives and friends who are 90 and they can’t remember what day it is and they can’t walk – this is not Christian virtue, just luck.†Well, it isn’t. Continue reading...
|
 |
by Ian Sample Science editor on (#1CX26)
With the final decision on vessel’s name imminent, a Commons committee will question NERC chief as part of an inquiry into science communicationMPs are to quiz the head of the Natural Environment Research Council on one the most contentious issues the organisation has ever faced: whether to call its £200m state-of-the-art research vessel RRS Boaty McBoatface.More used to pondering the state of the polar ice caps and humanity’s grave impact on the planet, Professor Duncan Wingham, a prominent climate scientist and chief executive of NERC, will spend Tuesday before the Commons science and technology committee fielding questions about NERC’s unexpectedly popular Name Our Ship competition.
|
 |
by Daniel Freeman and Jason Freeman on (#1CWNY)
The results of our experiment paint a very striking picture of the power of therapy involving VR in treating patients with persecutory delusionsIf you haven’t yet heard about Oculus Rift, chances are you soon will. Virtual reality (VR) headset technology – in the form of the Oculus and its main competitor the HTC Vive, both of which have just been launched on the consumer market – is about to make the leap into the mainstream. For the gaming industry, big bucks are in the offing. Facebook paid £2 billion to acquire Oculus Rift ; the returns, one imagines, could swiftly dwarf that figure.VR may be about to transform gaming, but the technology dates back to the late 1960s and the so-called Sword of Damocles. Bulky and relatively unsophisticated though it was, the main elements of VR were all present in the Sword. A computer generated an image, a display system presented the sensory information and a tracker fed back the user’s position and orientation in order to update the image. For the user, sensory data from the natural world was superseded by information about an imaginary world that changed in response to their actions. The result was what you’d experience with Oculus Rift or the Vive today: a “sense of presence†in an interactive, three-dimensional virtual world.
|
 |
by Hazel Cox and Geoff Cloke on (#1CWEY)
Chemist who won the Nobel prize for his role in discovering buckminsterfullerenes, also known as ‘buckyballs’Sir Harry Kroto, who has died aged 76, was awarded the Nobel prize in chemistry in 1996 for his part in the discovery of buckminsterfullerenes, also known as “buckyballs†– carbon atoms found in the form of a ball. In 1985 Harry, then professor of chemistry at the University of Sussex, had teamed up with Rick Smalley and Robert Curl, both professors of chemistry at Rice University, in Houston, Texas, to laser-vaporise carbon in laboratory experiments designed to simulate the chemistry of stars and interstellar space. Their experiments appeared to indicate that they had made an unexpected molecular species comprising 60 carbon atoms. This was amazing. Carbon had long been known to exist as diamond or graphite, but carbon as a small molecule required completely new thinking.This was where Harry drew on his artistic side and a knowledge of graphic design: he proposed that C was made up of a mixture of pentagons and hexagons, a structure known in ancient times, and now ubiquitous in footballs and in the work of the US architect and inventor Buckminster Fuller. But at first nobody could prove it, and many were openly sceptical. Continue reading...
|
 |
by Guardian Staff on (#1CW20)
Komodo dragon tops poll, compiled by scientists using Wikipedia page view data, that reveals our favourite reptiles are also among the scariest Continue reading...
|
 |
by Ian Sample Science editor on (#1CSGY)
Research gives glimpse of critical period of human development, sparking calls for debate on current 14-day legal limit for embryo experimentationResearchers have broken the record for growing human embryos in the lab, keeping them alive and active beyond the stage when they would naturally implant in a mother’s womb.The feat has been hailed as a milestone in the field, but the work by two teams of researchers in the US and the UK puts scientists into direct conflict with a decades-old law that prohibits donated embryos from being grown in the lab for more than 14 days. Continue reading...
|
 |
by Adam Kucharski on (#1CVB2)
Gambling is the vice that helped make the modern world. Here mathematician Adam Kucharski explains how casinos and card games inspired many ideas that are now fundamental to science.1. Dice games and the birth of a new scienceIn the 16 Century, there was no way to quantify luck. If someone rolled two sixes during a game of dice, people thought it was just good fortune. Gerolamo Cardano, an Italian physician with a lifelong gambling habit, thought otherwise. He decided to tackle betting games mathematically, and wrote a gamblers manual that outlined how to navigate the ‘sample space’ of possible events. For example, while two dice can land in 36 different ways, only one of these produces two sixes. Continue reading...
|
 |
by Associated Press in Hartford, Connecticut on (#1CT3H)
Charla Nash, who was mauled in 2009, returns to hospital where doctors hope ending experiment to wean her off anti-rejection drugs will reverse processA Connecticut woman who underwent a face transplant five years ago after being attacked by a chimpanzee is back in a Boston hospital after doctors discovered her body is rejecting the transplant.Related: Firefighter receives full face transplant in surgery called 'historic' Continue reading...
|
 |
by Ian Sample Science editor on (#1CSR9)
A shift in metabolic gear in our ancient ancestors means that humans burn calories much faster than any other primate, giving us energy for larger brainsThe hefty brains that set humans apart from other apes came into being when our ancient ancestors massively ramped up their metabolism, scientists say.The shift in metabolic gear, after the human lineage split from other primates, gave humans enough energy to run larger brains, have children in rapid succession, and live longer lives, the researchers found. Continue reading...
|
 |
by Peter Misra and Shanti Vijayaraghavan on (#1CSA1)
Our former teacher Noshir Wadia, known to us as “Profâ€, who has died aged 91, was a pioneering figure in Indian neurology.He was born in Surat, Gujarat, one of five children of Hormusji, a timber merchant, and his wife, Dinamai. He attended St Xavier’s school and obtained his medical qualification from the Grant Medical College in Mumbai (then Bombay). In 1951, after completing an MD, he travelled to the UK to train in neurology, spending four formative years as registrar to the pioneering neurologist Lord (Russell) Brain at the London hospital. Continue reading...
|
 |
by Tim Radford on (#1CRYY)
Why does the sun shine? How does the star work? Why is it mostly plasma, not gas? Green gives us the latest mind-stretching facts, and tells the story of the heroes of solar scienceWe rarely look directly at it but we miss it when we can’t see it. If it wasn’t there at all, we’d be gone too. It delivers the food we eat, the air we breathe, the clothes we wear. We read by its light – on a screen, on paper, indoors or out – because it is the ultimate energy source: indeed, the only energy source. It powered the primeval forests of carboniferous ferns and conifers that became our fossil fuel just as it drives the winds for the electrical turbines that must one day replace coal and oil. Even the radioactive elements whose decay and fission keep the planet alive and self-renewing are stellar confections: fragments first forged in, and then recycled by supernovae, exploding giant suns.That lucky old sun, the great Louis Armstrong sang, “has nothing to do but roll around heaven all dayâ€. In fact, it is the only thing in the solar system that really works hard: every second it converts 600m tonnes of hydrogen to 596m tonnes of helium and those missing 4m tonnes become the energy released by the thermonuclear reaction: a bonus of electromagnetic radiation distributed across the entire solar system. Continue reading...
|
 |
by Guardian Staff on (#1CRZ0)
Readers answer other readers’ questions on subjects ranging from trivial flights of fancy to profound scientific conceptsWhich is more complicated, rocket science or brain surgery?
|
 |
by Jon Butterworth on (#1CRX2)
Perimeter Institute public lecture by Tim Palmer of Oxford University
|
 |
by Sarah Cefai on (#1CRKR)
Rather than display James Cook’s ship in a traditional museum, why not entrust it to a First Nations co-operative?News has emerged confirming the whereabouts of the wreckage of HMS Endeavour, a ship sailed by Captain James Cook. Reports invariably contain images of the ship in its pomp, proudly reminding the reader of its British origins and its voyage to the Pacific Ocean, where Cook took possession of Australia. But where should Cook’s ship go? Once we dredge it up, or rather, once the Rhode Island Marine Archaeology Project dredges it up, where should it be put? And will Cook’s ship be allowed to take us beyond our colonial past?It must be remembered that it is our cultural attachment that will be doing the dredging, our obsession and fascination with these objects that circulate as evidence of the all-powerful histories of empire. Where we decide to put Cook’s ship and its contents will shape where it takes us. Through its presentation we will relate to it culturally; as an object of desire or fascination for some, and boredom for others. We will tell a new story and it will make us feel something. Continue reading...
|
 |
by Elsa Panciroli on (#1CQZ4)
The invertebrate fossil record from amber provides insights into evolutionary history, and the climate of Earth’s past ecosystems“It’s all about the genitals. It’s often the only way to tell the difference between them.â€I tried not to choke on my coffee as palaeoentomologist Richard Kelly explained the intricacies of his field of research – the study of fossil insects - during a refreshment break. “Genitalia are usually internal when they’re not being used, or when the animal is dead. There was this one guy who invented a special device for extracting fly genitals. I can’t remember his name though…†Continue reading...
|
 |
by Alan Yuhas on (#1CQNX)
The ship in which the explorer charted New Zealand, Australia and the Pacific ended its life sold, renamed and scuttled in the war to keep America BritishCaptain James Cook observed the transit of Venus from the shores of Tahiti, ran aground on the Great Barrier Reef and claimed Australia for the British crown. He fought the French in the Americas, circumnavigated the world and died trying to kidnap a king of Hawaii.Related: Wreckage of Captain James Cook's ship Endeavour found, researchers say Continue reading...
|
 |
by Press Association on (#1CQQ8)
Biologist who saved nine species from extinction has been given the Indianapolis Prize for conservationA biologist from Wales who saved nine species from extinction has been given a prestigious environmental award.Prof Carl Jones has been awarded the 2016 Indianapolis Prize, often dubbed the “Nobel prize†of conservationism. Continue reading...
|
 |
by Will Self on (#1CQQ6)
Anyone with a smartphone anywhere on Earth knows exactly where they are. But does that leave us lost?In early 2008, for quixotic reasons that needn’t detain us here, I decided to walk from Dubai airport across the city and into the Empty Quarter of Arabia. Prior to departure, at home in London, I tried to figure out a way of reaching, on foot, the desert resort of Bab al Shams, which lay about 15 miles beyond the city’s ragged fringe of buy-to-let building sites. There were some tourist maps that showed the downtown area and a few primary arterial routes, but there was nothing available that had both the necessary scale for a walker – 1:25,000 or better – and sufficiently accurate orientation to enable compass bearings. While the local Bedouin may to this day retain a mental map of the area, collating a myriad of little positional markers – environmental, solar and sidereal – in order to determine location and direction, everyone else presumably relied on the GPS navigation systems in their air-conditioned cars.In the end I hit on the simple if deranging idea of laying a 12in ruler against a Google Earth satellite photograph of the desert on my computer screen. This did indeed give me a means of dead-reckoning, but I had no way of determining distance accurately, and when I left the last pile of dusty breezeblocks behind and headed into the dunes, following the flickering needle of my compass, it was with the understanding I might well be spending the night beneath the stars. In fact, the bearing proved sound enough, and I arrived at the resort hotel well after dark to be informed by the receptionist (who was from Selly Oak) that there’d be no alcohol served that night because it was the Prophet’s birthday. Continue reading...
|
 |
by Amanda Holpuch in New York on (#1CPMT)
|
|
by Jessica Glenza in New York on (#1CPAA)
Study finds more than half of US population receives prescription annually and estimates ‘inappropriate’ prescriptions in doctor’s office setting at up to 30%Nearly one-third of Americans prescribed antibiotics during doctor’s office visits probably should not have received the drugs, were not given a long enough course or did not get the right dose, according to new research.The new study into how doctors prescribe antibiotics to Americans in outpatient settings comes as rates of antibiotic resistant bacterial infections are on the rise. Up to 23,000 Americans die and 2 million more become sick due to antibiotic resistant bacteria each year, according to the Centers for Disease Control and Prevention (CDC), and scientists have found rates of such infections on the rise. Continue reading...
|
 |
by Mary Dejevsky on (#1CP4G)
I hope the latest breast cancer breakthrough is genuine. But I also wish we paid as much attention to other severe conditionsI prefer to give a wide berth to boasts about dragon-slaying medical breakthroughs. Perhaps it’s the awareness that the hopes raised tend to be fleeting, or that the actual arrival of a new treatment, even a cure, lies many years away.Yet a new study, published this week in Nature, seemed to warrant a closer look. It appears that researchers at the Sanger Institute at Cambridge now have what was described as “a near-perfect picture of the genetic events that cause breast cancerâ€. They have identified most of the genetic mutations that cause healthy breast tissue to misbehave. The prospect of individually tailored, effective, treatment would thus seem to have come a whole lot closer. Continue reading...
|
 |
by Nicola Davis on (#1CNXT)
Study found horses’ heart rates increased and they struggled to chew when nosebands were over-tightened, leading to calls for stricter regulations on useResearchers studying the physiological impact of nosebands on horses competing in international equestrian competitions including the Olympics are calling for new regulations to reduce potential pain and distress from the equipment.The scientists found that horses’ heart rates were raised and they struggled to chew when nosebands were fitted too tightly around the animals’ heads. Continue reading...
|
 |
by Frank Knowles on (#1CNSB)
My sister, Barbara Knowles, who has died aged 55, was an enthusiastic biologist, a scientific adviser to the Royal Society of Biology (RSB) and a champion of meadow ecology and sustainable development projects, especially in Transylvania.She worked in the Pogány-havas region of the eastern Carpathians with local volunteers and experts to record and protect valuable flora and fauna. She established the Barbara Knowles Fund and supported activities working with schoolchildren, academics and policymakers. Continue reading...
|
 |
by Nicola Davis on (#1CNFM)
A study of labrador DNA revealed more than a fifth of the dogs carry a genetic variation which could predispose them to food-seeking and weight gainLabrador dogs are well known for being fond of their food, but new research suggests their greedy nature could be down to genetic mutation.Labrador retrievers are top dog in the UK, with 32,507 animals newly registered with the Kennel Club in 2015 alone. But the breed is well known for its tendency to develop a portly form, a concern given the variety of health problems - from diabetes to heart disease - linked to obesity. Continue reading...
|
 |
by Alison Flood on (#1CNBY)
Brilliant work in the archives has unearthed evidence that the great ornithological artist also enjoyed some rather more fanciful workArtist and naturalist John James Audubon was a master of ornithological illustration, and also, it turns out, master of the prank.A new paper in the journal Archives of Natural History, Pranked By Audubon, sees the Smithsonian Museum of Natural History curator Neal Woodman lay out how the author of The Birds of America took time out from his superb illustrations to invent a series of “wild rats of the western states†and other creations with which to fool the naturalist Constantine Rafinesque. Continue reading...
|
 |
by Ian Sample Science editor on (#1CMW2)
Water seeping to the surface during the Martian summer might boil so violently it blasts dust off the ground, helping to explain the size of the streaksMysterious streaks that appear on the steep slopes of Mars may form when seeping water boils with such violence that it blasts dust off the ground.The seasonal tracks come into being in the summer months on Mars and grow for hundreds of metres down cliffs, gullies and crater walls, before they vanish again in the winter.
|
 |
by Ian Sample Science editor on (#1CMA2)
Following their February breakthrough, Kip Thorne, Rainer Weiss, Ronald Drever and nearly 1,000 LIGO scientists will share the Silicon Valley-backed prizeMere months after they declared the discovery of gravitational waves, more than 1,000 physicists have been handed good reason to put their party hats back on and return to the champagne.The February observation of ripples in the fabric of spacetime, first postulated by Albert Einstein a century ago, has landed the researchers $3m (£2.04m) in the shape of a prize backed by Silicon Valley entrepreneurs. Continue reading...
|
 |
by Benjamin Lee on (#1CM8X)
Media mogul takes role as the daughter of Baltimore woman who unwittingly contributed to vital medical researchOprah Winfrey is to take on a rare acting role in a new film about Henrietta Lacks, a woman whose cells became instrumental in the field of medical research.According to Deadline, the media mogul will headline The Immortal Life of Henrietta Lacks, a film for HBO that she will also executive produce. Winfrey has teamed up with Six Feet Under creator Alan Ball, and George C Wolfe, best known for his stage work, who will write and direct. Continue reading...
|
 |
by Michael Slezak on (#1CM21)
One Senate committee member has also called on the government to consider replacing CSIRO chief executive Larry Marshall over the planned cutsThe government must act to halt the CSIRO’s plans to cut its climate science program, a Senate committee has recommended, with one committee member calling on the government to consider replacing the chief executive over the debacle.In February, the CSIRO announced it would be sacking about 100 of its 140 climate scientists, chief executive Larry Marshall saying the science was settled on climate change and it was time to move on to questions of adaptation and mitigation. Continue reading...
|
 |
by AFP in New York on (#1CJMC)
The Rhode Island Marine Archaeology Project appears to have located the British explorer’s vessel off US coast where it was sunk during the revolutionary warResearchers said they believe they have located the wreckage of the Endeavour, a ship sailed by the famous British explorer James Cook, which was sunk off the US during the revolutionary war.The ship was scuttled in 1778 leading up to the Battle of Rhode Island between American colonists and the British, and was as part of a blockade during the revolutionary war. Continue reading...
|
 |
by Nicola Davis on (#1CJAK)
Research indicates that cancers are highly individual and would therefore respond best to individualised treatmentsPersonalised treatment for breast cancer patients could become commonplace, as scientists reveal that they have compiled the most detailed picture yet of which genetic mutations are involved in the disease.
|
 |
by Nicola Davis on (#1CHZ0)
Lord Rees and Richard Dawkins lead tributes to British scientist best known for creating carbon-based molecule buckminsterfullereneSir Harry Kroto, the British Nobel prize-winning chemist who co-discovered a new form of carbon, has died aged 76.Kroto is best known for his role in revealing that carbon can exist in the form of a hollow football-like structure. Named “buckminsterfullerene†after the similarly shaped domed buildings produced by the American architect Buckminster Fuller, these structures soon became known as “buckyballsâ€. Continue reading...
|
 |
by Ian Sample Science editor on (#1CH7A)
Three Earth-sized planets are thought to have surface temperatures which would allow liquid water, making them potentially hospitable to lifeThree distant worlds that orbit a feeble star in the constellation of Aquarius are the most likely places discovered so far to find life beyond the solar system, astronomers say.Related: Kepler 438b: Most Earth-like planet ever discovered could be home for alien life Continue reading...
|
 |
by Alfred Hickling on (#1CGC0)
Northern Stage, Newcastle
|
 |
by Goedele Liekens on (#1CG33)
Much of the response to the TV show is connected to the shame and guilt surrounding lovemaking. As a sexologist, I want to break down those taboosLooking at the Twitter explosion after the first episode of Sex Box aired on Channel 4 it seemed that many Brits were shocked to learn that some people wanted to come on television to have sex in a box and talk about their sex lives. I will admit that it’s not for everyone, but for some of them, going into the box added a sort of frisson to the entire experience. Which isn’t surprising – it’s not unusual for us to find arousal in unlikely places.For others, the box was a reason for them to have a conversation about trying something different or new together for the first time. And though that may sound scary, it wasn’t really. I was always there to talk each couple through their experience, offering any tips and advice as and when they needed it. Continue reading...
|
 |
by Carey Davies on (#1CFP2)
Ribblesdale, Yorkshire Dales Sheep graze around giant boulders dropped by glaciers, picking the land as clean as the ice once did
|
 |
by Rajeev Syal on (#1CF41)
Former Labour leader joins environment secretary Liz Truss and Green MP Caroline Lucas in supporting remain campaignEd Miliband has joined a cross-party attempt to persuade voters that leaving the EU would damage the environment.The former Labour leader has signed a joint declaration with environment secretary Liz Truss, former energy secretary Ed Davey and Green Party MP Caroline Lucas in what pro-EU campaigners called an unprecedented partnership.
|
 |
by Associated Press in Cincinnati on (#1CEFR)
|
 |
by Kate Ravilious on (#1CET2)
Roughly every other week a one-metre-wide asteroid impacts on Earth’s atmosphere and creates a spectacular fireball. Meanwhile, every few decades a lump of rock the size of a double-decker bus comes our way, creating a small crater on the ground like the Russian Chelyabinsk event on 15 February 2013.Asteroids that cause significant damage (football-field-sized rocks) slam into us every 5,000 years or so, and the real biggies – capable of causing global disaster – arrive every few million years. Continue reading...
|
 |
by Letters on (#1CEMR)
Contrasting Greens | Doctors’ strike | Pointless prefixes | A rare actress | Politician-kissing babyCongratulations on your editorial finesse. Page 4 of last Friday’s Guardian had photos of two Greens. One was a knighted establishment figure who sold a high street chain store after taking out millions of pounds in dividends, leaving a massive pensions hole in a firm that has now collapsed, putting 11,000 jobs at risk. The other is an elected member of parliament. Only one of these Greens has been spied on by the police. Is this what is meant by a democratic deficit?
|
 |
by Paul Manning on (#1CE42)
In the late 1980s I was a scientist at the Royal Signals and Radar Establishment in Malvern. David MacKay was placed with our team as our summer student for two months’ work experience. It rapidly became clear that not only did he fit well into our small thermal imaging research team, but he was able to complete the tasks we allocated to him in about half the time we would normally expect for a student.In his final week we ran out of jobs, so we suggested he could do his own little project. He presented us with an astrolabe made from cardboard and odds and ends found round the lab, with the appropriate azimuth and altitude circles for Malvern plotted on plastic transparencies using our lab plotter. When he left to go back to his second undergraduate year, we were sure he was heading for great things. Continue reading...
|
 |
by Guardian Staff on (#1CE2N)
Test your pawprint identification skills and your knowledge of native species with our nature quizWhich of the following animal paw prints belong to a fox?abcdWhich of these edible plants isn't associated with the seashore?SamphireSea PeaThree-cornered leekSea BeetWhich is the odd one out and why?Agaricus xanthodermus, yellow stainerBoletus edulis, the penny bunAgaricus arvensis, the horse mushroomCalvatia gigantea, the giant puffballWhat animal's scientific name is Cupido minimus?Red foxEuropean otterSmall blue butterflyWrenWhich of the following bird names do you complete with tern?The roseate …The marsh …The long-tailed …The Coal...Which bird is the odd one out and why?CuckooTurtle doveSwiftWrenWhich of these creatives is a non-native arrival in this country?Harlequin ladybirdSeven-spotRoe deerWhat has been successfully brought back from extinction in Britain just next to the nuclear power stations at Dungeness in Kent?The great bustardThe craneThe short-haired bumblebeeThe large blue butterflyWhat species is most commonly found on Isle of Mull, Scotland?The red-barbed antThe white-tailed eagleThe red squirrelThe lundy cabbageNature reserves. Identify which of these lovely wild places is The North York Moors, Yorkshireabcd Continue reading...
|
 |
by Jon Butterworth on (#1CDG9)
Scientists deployed a new political technology twice this week, to spectacular effectOn Thursday I was on BBC Radio 4’s Inside Science, discussing with Adam Rutherford some excitement around the new data from CERN’s Large Hadron Collider. Under his newly-invented ‘Cloak of Speculation’, we mused as to whether the currently statistically-marginal blip might develop into the first evidence for a new particle, perhaps some kinds of heavier version of the Higgs boson, or maybe even some kind of graviton looped over higher dimensions of spacetime. You can listen to us here.Eventually, someone is going to ask ‘Who threw the dead cat?’ Continue reading...
|
 |
by Andrew Anthony on (#1CD8R)
Long known as the ninth planet, Pluto was downgraded in 2006, sparking a scientific spat that raises basic questions about how we understand the universeImagine that you have nurtured an ambition for 25 years to head up an expedition to the last unexplored planet in the solar system. You’ve worked your way up and through countless other suborbital, orbital and planetary missions. You’ve written scores of scientific papers. Finally, you are the principal investigator on Nasa’s New Horizons mission to Pluto – that mysterious little entity, a third of the size of our moon, that is located, depending on orbital position, between 2.6bn and 4.7bn miles from Earth.In January 2006, your probe leaves Earth on its nine-year journey to its historic destination. It is the crowning moment of your career, a landmark project; you’ve reached the peak of your profession. Then, seven months later, with your spacecraft still in the early stages of its odyssey, it is announced, following a vote at a meeting of the International Astronomy Union (IAU) in Prague, that Pluto is no longer a planet. Continue reading...
|